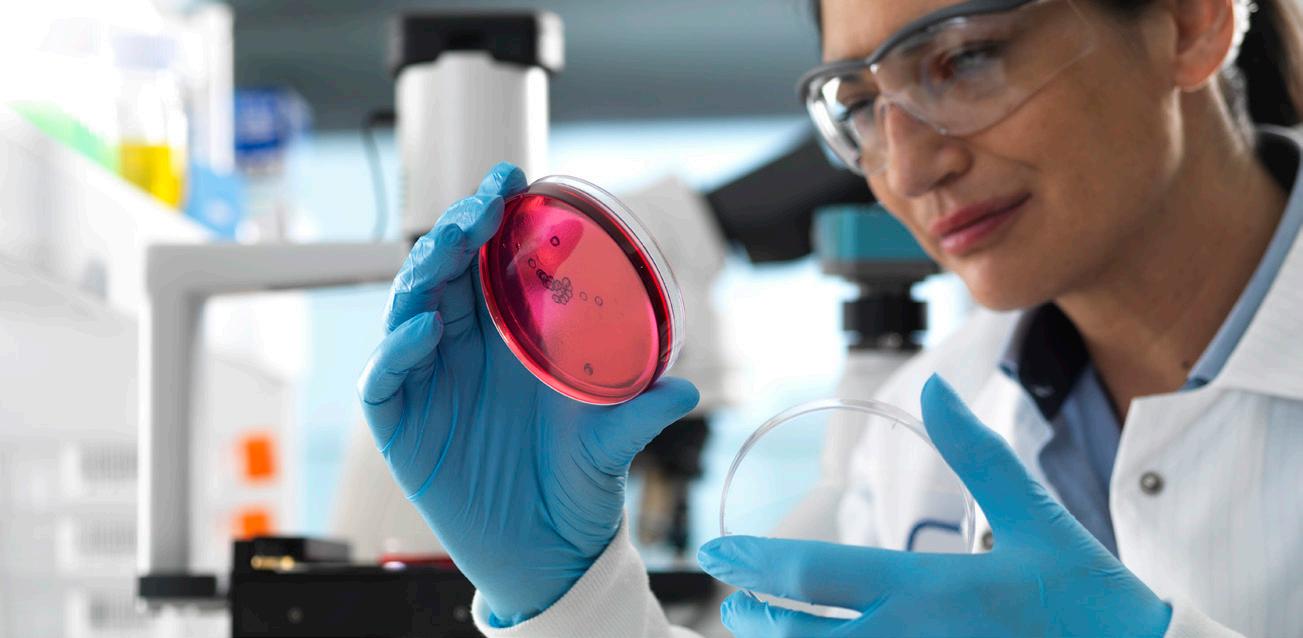

Living With HIV & AIDS
“We want to make sure that people understand that HIV is still very much alive and thriving in the queer community, especially for queer people of color.”
Alexandra Billings, Actress, Singer, and Professor Page 06
“We can end AIDS and any pandemic only if we reach everyone, everywhere — including here in America.”
Regan Hofmann, Senior Advisor, UNAIDS Page 08


June 2024 | www.futureofpersonalhealth.com
An independent supplement by Mediaplanet to USA Today
ZACH WILLMORE
importance
open about
Read more on Page 04
The social media star discusses the
of accepting and being
his HIV diagnosis
Advocating to End the HIV Epidemic for All Black Women

Founded in 2010 through the merger of AIDS Action and the National AIDS Fund, AIDS United has remained unwavering in its commitment to end the HIV epidemic in the United States through strategic grantmaking, policy and advocacy, and capacity building.


Our mission is deeply rooted in racial justice, recognizing that the fight against HIV/AIDS cannot be separated from the broader struggle for equality and human rights. Marginalized communities, including Black women, are disproportionately impacted by the epidemic due to systemic inequities such as inadequate healthcare access, economic disparities, and pervasive discrimination. At AIDS United, we understand that addressing these social justice issues is crucial for effective HIV prevention and treatment. We tirelessly advocate for policies and programs prioritizing the needs of the most impacted communities, aiming to dismantle the systemic barriers perpetuating vulnerability.
Disproportionate effects
As one of our advocates shares, “I am a patient navigator and an advocate for the community. I love empowering and uplifting women and children of color. I was born with HIV, and I believe in thriving with HIV.”
The statistics are stark: Black women account for 60% of new HIV diagnoses among women in the United States despite representing only 13% of the female population. Black transgender women face an even higher risk,

underscoring the urgent need for focused interventions and new methods for our toolbox.
One method in AIDS United’s toolbox is the Melanated Movement Initiative, a groundbreaking program designed to uplift Black communities and address the disproportionate impact of HIV/AIDS among Black women of all experiences. The role of women in their communities to spread education is vital to addressing the HIV disparity that affects all people, making their input crucial to HIV prevention as well as care.
Ending the epidemic
Ending the HIV/AIDS epidemic for Black women requires a multifaceted approach. Comprehensive sex education, access to quality healthcare services, and addressing social determinants of health are essential components. The Melanated Movement Initiative exemplifies our dedication to partnership and allyship. Harnessing the collective power of both individuals and institutions, such as Youth and Historically Black Colleges and Universities (HBCUs), the Melanated Movement Initiative strives to drive meaningful change within Black communities, regardless of age or proximity to resources.
Comprehensive sex education that is inclusive and culturally sensitive is essential. This education should
encompass topics like safe sex practices, consent, and HIV prevention methods, including pre-exposure prophylaxis (PrEP), while expanding access to quality healthcare services.
This effort includes making HIV testing readily available, ensuring access to antiretroviral therapy for those living with HIV, and providing mental health support to address the stigma and psychological impact associated with the disease.
As another advocate explains, “I got on PrEP because I wanted to lead by example. How can I be an advocate and educator and not lead by example? I am a single, cis[gender] Black woman living in Atlanta who is sexually active. I like it because it puts my sexual health in my hands and not on my partner.”
The future is one of health equity, where systemic barriers are dismantled, and all individuals, regardless of their background, can access the care and support they need. AIDS United’s work to end the HIV/AIDS epidemic in the United States is a testament to the power of compassion, collaboration, and relentless advocacy. By focusing on empowerment, partnership, and advocacy, we are paving the way for a future where HIV/ AIDS is no longer a public health crisis, but a chapter in history. The fight continues, fueled by a vision of a world where everyone can live with dignity, free from the shadow of HIV/AIDS.
02 MEDIAPLANET READ MORE AT FUTUREOFPERSONALHEALTH.COM
@futureofpersonalhealth Contact information: US.editorial@mediaplanet.com @MediaplanetUSA Please recycle Publisher Aaron Palmer Managing Director Gretchen Pancak Production Manager Dustin Brennan Copy Editor Taylor Rice Creative Director Kylie Armishaw Cover Photo Credit Scott Shannon Schaefer All photos are credited to Getty Images unless otherwise specified. This section was created by Mediaplanet and did not involve USA Today. As the country unites to end the HIV epidemic, AIDS United stands at the forefront, strengthening and driving the engine forward.
AIDS
WRITTEN BY Carli Gray Program Associate,
United
AIDS United WRITTEN BY D.
Senior Communications Manager, AIDS United
WRITTEN BY Athena Cross, Dr.P.H. Vice President,
D’Ontace Keyes
Photo courtesy of AIDS United, See Through My Lens Photography
Unlocking the End of the HIV Epidemic
Tremendous progress has been made in the effort to end the HIV epidemic since the first official case was reported more than 40 years ago. However, efforts to control the ongoing HIV epidemic have continued to be hindered by decades of widespread misconception, stigma, and discrimination.
Gilead Sciences, a healthcare industry leader committed to advancing health equity, knows it will take more than medicine to end the HIV epidemic. The company, in partnership with community leaders and advocates, is dedicated to helping raise awareness about the negative effects of HIV-related stigma as a major barrier to HIV testing, prevention, and treatment.
Testing
Knowing your HIV status through HIV testing is an important part of your self-care and gives you powerful information to help you and your loved ones stay healthy.
Of the roughly 1.2 million Americans living with HIV in 2019, 13% did not realize they were carrying the virus. That’s why the CDC recommends that everyone between the ages of 13 and 64 gets tested for HIV at least once as part of their routine healthcare plan. Some people should continue to get tested on a regular basis and start a dialogue with their healthcare providers about their status even if their HIV test was negative more than 1 year ago.
“Destigmatizing HIV testing is crucial to our efforts to help end the HIV epidemic and helps us achieve changing how sexual health is viewed, especially in communities experiencing health disparities that are fueled by barriers like misconceptions and stigma,” said Leandro Rodriguez, Vice President of The Latino Commission on AIDS, a Gilead grant recipient. “There is a disproportionate impact of HIV on Black, Hispanic/Latino/a/x and LGBTQ+ communities, and we know that raising awareness of testing and next steps – among the community
and with healthcare providers – is a foundational piece towards dismantling stigma and promoting uptake of prevention or treatment services.”
Treatment
Low awareness and stigma can lead to fear around HIV, but knowing your status can help empower you to talk to a healthcare provider to discuss the best HIV care for you. It’s especially important that everyone who is diagnosed with HIV see a healthcare provider and begin treatment as soon as possible – no matter how long they’ve had HIV or how healthy they believe they are.
Stigma has also been linked to improper HIV treatment adherence, which can impact the ability of treatment to suppress the virus. Current research shows that taking HIV treatment as prescribed, getting to an undetectable viral load (levels of HIV so low it cannot be detected), and staying undetectable for at least 6 months prevents transmitting HIV to others through sex. This is known as U=U (Undetectable=Untransmittable) or TasP (treatment as prevention). HIV treatment can help people with HIV live longer, healthier lives and can help reduce the chance of passing HIV to others through sex.
Prevention
One of the key methods for helping prevent HIV is pre-exposure prophylaxis, or PrEP — a prescription medicine people can take before being exposed to HIV that reduces the likelihood of contracting the virus.
PrEP reduces the likelihood of contracting HIV from sex by about 99% when taken as prescribed, according to the CDC. Yet, only about 30% of the 1.2 million people in the US who could benefit from PrEP were taking it at the
end of 2021. PrEP is for people who are HIV-negative and does not protect against other STIs, so people should be sure to use condoms and other healthy sex practices while on PrEP.
The national goal is to raise that figure to 50% by 2025, which will require dismantling long-standing stigmas and barriers to accessing HIV prevention services, especially among Black and Latinx communities that have long been disproportionately impacted by this health crisis and many others. Healthcare providers also play a role by having conversations about HIV prevention options and sexual health with their patients.
“Prevention is key to helping end the HIV epidemic, but barriers to access and uptake of PrEP like stigma and health disparities are hindering progress,” said Sandrine Piret-Gerard, Senior Vice President, U.S. Commercial at Gilead. “It’s critical that we collaborate with community leaders and healthcare providers to help eliminate barriers to PrEP access and uptake, including those that occur at points of care, such as misperceptions and low awareness of who is eligible for PrEP, so that we can improve uptake of prevention medicines and help limit forward transmission of HIV.”
While there is no cure for HIV, increasing testing efforts and encouraging uptake of treatment or prevention options as early as possible following a test can help end the HIV epidemic. To realize those goals, we must all work together to break down harmful stigmas and systemic barriers to HIV care through education, awareness, and advocacy.
If you have questions about HIV treatment or prevention options, talk to a healthcare provider.
Written by Gilead Sciences


To find nearby HIV testing, order a free at-home test, and learn what to do after receiving results, visit hivtestnow.com

GILEAD and the GILEAD Logo are trademarks of Gilead Sciences, Inc., or its related companies. All other marks are the property of their respective owners.
© 2024 Gilead Sciences, Inc. All rights reserved. US-UNBC-2203 05/24
03 MEDIAPLANET READ MORE AT FUTUREOFPERSONALHEALTH.COM
Sponsored
INTERVIEW WITH Leandro Rodriguez Vice President, The Latino Commission on AIDS
INTERVIEW WITH Sandrine Piret-Gerard Senior Vice President, U.S. Commercial, Gilead
Helping The LGBTQ+ Community Access Better HIV Care
Dr. Joshua Gonzalez is a board-certified urologist specializing in male and female sexual dysfunction, and co-founder of the supplement brand Popstar Labs. He shared some of the biggest myths surrounding HIV and AIDS, and how providers can help LGBTQ+ individuals access better care.
What are some common misconceptions or myths about HIV/AIDS that you frequently encounter in your practice, and how do you address them?
One of the biggest misconceptions about HIV we encounter is regarding transmission of HIV through sex. If someone living with HIV is on appropriate medical therapy and has an undetectable viral load, they cannot transmit the virus through sex. This has been shown in multiple studies. Undetectable = Un-transmittable. Period.
Can you share any strategies or approaches for creating inclusive and supportive healthcare environments for LGBTQ+ individuals and others affected by HIV/AIDS?
Making sure to have paperwork and materials that are inclusive is a very easy way to create supportive healthcare environments for LGBTQ+ individuals. Ask for specifics: How does someone identify? What is their sexual orientation? What pronouns do they prefer? All of these questions are important to not only foster a supportive environment, but they can be extremely helpful from a clinical perspective as well.
Healthcare providers should also avoid making assumptions about someone based on how they identify. For instance, never assume that just because someone identifies as a member of the LGBTQ+ community that they are engaging in a specific sexual activity or aren’t interested in fertility and reproductive health. I’ve seen far too often patients feel judged or neglected because of assumptions their provider made.



TikTok Creator Zach Willmore on Vlogging Life With HIV
19-year-old TikTok creator Zach Willmore is empowering his community of more than 2 million followers by openly discussing his life with HIV.
When did you first start your journey into social media and content creation? I started my journey into social media my sophomore year of high school. Right before quarantine, one of my friends told me that they thought I had the personality for it. After that, with all the time I had during quarantine, I was really able to explore who I wanted to be as a creator.
What made you decide to share your diagnosis on social media?
Can you speak to the importance of LGBTQ+ visibility and HIV representation in social media?
Visibility is one of the most important things when it comes to HIV. I cannot tell you how many DMs I’ve received telling me that I have saved someone’s life by sharing my story. By keeping keeping your HIV diagnosis quiet and not talking about it at all, it makes people feel ashamed. It’s hard to see the big picture when you don’t see anyone else living through the same situation you are in.
INTERVIEW WITH
Joshua Gonzalez, M.D. Board-Certified Urologist, Co-Founder, Popstar Labs
When I got diagnosed with HIV, I started making video diaries to help myself process it. The reason I decided to post them was to help other people. There is a reason that they have you come into the office to give you your diagnosis instead of telling you on the phone, and why they give you a social worker after that diagnosis. Suicide rates are disproportionately high for people who receive HIV diagnoses. Without the support system I had, I also would have been at risk of becoming a statistic. I wanted to help people without that support system by showing what life is like after the diagnosis. It’s awful that people feel like they have to throw away something so valuable for something that’s completely treatable.
What advice would you give to others who may be navigating a similar journey or facing an HIV diagnosis?
I think it’s important to recognize that a lot of the stigma is in our own heads. At the beginning of my diagnosis, I would legitimately block myself out of romantic relationships because I would tell myself that I wasn’t deserving of one. I had to start trusting people when they said they were OK with my diagnosis instead of always assuming the worst. That’s why when I finally was ready to have a boyfriend, I was also finally OK with the idea of living with an HIV diagnosis.
04 MEDIAPLANET READ MORE AT FUTUREOFPERSONALHEALTH.COM
Zach Willmore | Photo by Scott Shannon Schaefer











cobas® HIV-1/HIV-2
Qualitative PCR Test can detect infection significantly earlier† than standard serology testing, empowering you to take action sooner.

With the sensitive and accurate detection capabilities of PCR, you can stop wondering - now is the time for peace of mind.


FUTUREOFPERSONALHEALTH.COM
The
cobas® HIV-1/HIV-2 Qualitative 09198695001-04EN Rev. 4.0 Instructions for Use
go.roche.com/HIV †
Revolutionizing HIV Care: The Black AIDS Institute’s Mission to Sterilize Stigma in the Black Community
In their 25th year, the Black AIDS Institute (BAI) tackles the disproportionate impact of HIV in the Black community through education, advocacy, and love.
What is BAI’s mission?
Acknowledging that health is an entitlement anchored in social justice, BAI is working to revolutionize the HIV response in Black America — intergeneration-ally. This is the cornerstone of all Black cultures. Paramount to this task is centering Black women and stigma sterilization.
What can be done to reverse rates of HIV in Black Americans, particularly Black women?
Today, HIV is a cyclical virus, except in Black communities. White gay men in the United States will be virally suppressed before the government target date of 2030. We have the biomedical interventions. The question is this: How are HIV prevention and care modalities communicated to Black women?
This is not a question to be provocative or to throw a flame. It is simply to illustrate that if Black women in our communities are not informed and educated, we cannot expect to have positive and sustainable outcomes in our communities regarding HIV, or any other health matter.
The best example is PrEP. PrEP is available to many, but the conversation must be reconfigured for the Black community as a whole. Many Black women are unaware of this amazing medical tool — and that if you’re HIVnegative, you can remain that way and enjoy a healthy, vibrant sex life.
In order to truly reduce the rates of HIV for my (Black) people, we must rapidly commit federal, state, local, and private funds and energy to revolutionizing the prevention and care model and messaging.
Interview with Grazell Howard,
Chairperson, Board of Directors, Black AIDS Institute
Alexandra Billings on Fighting Stigma and Remembering History in the Battle Against
HIV

Actress, singer, and professor Alexandra Billings sheds light on the ongoing struggles of LGBTQ+ individuals against HIV discrimination, and how remembering our history can help.
Did you experience any stigma surrounding HIV and AIDS when you were first diagnosed?
The prejudice that surrounded us when we were in our 20s was completely unexpected. Because of the gay liberation movement, we were all going, “Hey, we get to have sex with each other. Hurray, finally!” Then (because of the HIV epidemic), everybody went, “Yes, and then you’ll die.”
Not only that, but the government went “Fantastic! This is great. Now we don’t have to worry about it [the LGBTQ community], they’ll all be dead. Then we’ll just carry on!” That still rings in my ear.
What was that like to endure and stand up to?
I used to do this, the whole room shifted. I mean, you could feel that people were horrified for me.
Now I say it, and it’s like I just said, “Pass the peanut butter.” Now people are so disconnected from it, which in a way is good. At the same time, we want to make sure that people understand that HIV is still very much alive and thriving in the queer community, especially for queer people of color.
Nobody considered themselves courageous or brave in any way. We were literally just trying to survive.
Nobody considered themselves courageous or brave in any way. We were literally just trying to survive. As people were dying, we had to save what was left of our community, or we knew we would all expire. We knew that’s what they wanted. We marched because we had to, not because we wanted to.
What changes have you seen in how the public responds to HIV and AIDS?
I’m a professor at the University of Southern California where I teach acting, and I have an exercise called “5 Facts About Us.” I always write, “I have AIDS.” When
Why is it still so important that we keep on talking about HIV and AIDS?
There are lives to be saved. I mean, it really is that simple. It’s still happening, it’s still blossoming, it’s still flourishing. Yes, there are life-saving medications, but those medications have unbelievable side effects. Some people can’t tolerate them, and a lot of queer people still don’t have insurance.
We have a lot to deal with here. It’s not always as simple as taking one pill. We need to remember that this has a history of revolution that’s attached to it.
When we talk about this disease, we have to talk about the humans who gave their lives so that we can survive today, and remember that our community is based on revolution. We cannot lose the history of queerness in HIV. We need to listen, listen, listen more, and pay attention, because it’s not going anywhere.
06 MEDIAPLANET READ MORE AT FUTUREOFPERSONALHEALTH.COM



Changing the Course of the HIV/AIDS Epidemic for Women
We spoke with Krista Martel, Olivia G. Ford, and Ciarra Covin, staff members of The Well Project — which aims to change the course of the HIV/AIDS epidemic, especially for women — about what has changed since the organization was founded, and strategies for dismantling stigma and other barriers to care.
How did The Well Project get started?
Krista Martel: The Well Project was started in 2002 by a woman living with HIV, Dawn Averitt. Averitt was diagnosed in the late ‘80s at the age of 19. She ended up working in Atlanta at a community-based organization — they basically handed her a bunch of books and said, “Start reading up.”
She, like many other HIV activists, got very knowledgeable about the research and clinical trials, and quickly saw how little information there was around women with HIV. At a certain point, she had this idea: “What if there was a place where we could put all this information about women and HIV?” It would be a resource that people could access and bring back to their communities — not just for people living with HIV, but also for their care providers, and family and friends.
So that was the concept of The Well Project. It’s about the
whole woman — not just about treatment, but holistic wellness. The well is a symbol of gathering and coming together to exchange information and disseminate it within your community.
What changes have you seen in the HIV and AIDS landscape, especially pertaining to women?
Olivia G. Ford: The H in HIV stands for human. It’s a health condition that people acquire by doing things that human beings do, and it’s worth noting that we have tools to manage HIV. What continues to be a stumbling block to progress is stigma. An HIV diagnosis rides the coattails of existing stigmas: systemic racism, patriarchy, and sexism, and we can’t end HIV as an epidemic without consciously addressing those stigmas. These systems have entrenched HIV stigma and keep in place policies that punish people for who they are. We see all sorts of ways that control
over Black women’s bodies gets enacted. It’s taken decades for women to get the information from providers that women who are on effective treatment can have babies without passing on the virus.
What is the “A Girl Like Me” blog, and how has it helped women living with HIV?
KM: When I joined The Well Project in 2009, there was a very small grant to start a blog, and there was no kind of direction on how to do it or what it should look like. It was a very organic process. It was word of mouth — people just started coming in and sharing.
Bloggers can write about whatever they want — and can blog anonymously, because we want it to be a safe space for people to be able to share their experiences and connect with each other. What’s so powerful about it is that other people can see themselves represented in the experiences people share. It makes people feel less alone.
Ciarra Covin: As a woman living with HIV, finding the “A Girl Like Me” community unveiled so many different members of my community that I probably would have never met. It was the first time I had ever seen so many women who were living with HIV sharing their stories. When I go into the doctor’s office, there’s almost never anybody in there who looks like me.
Through “A Girl Like Me,” I’ve found other community members who affirmed I was not going crazy, because sometimes you feel isolated and alone thinking you’re the only person living with it, that you’re the only person who’s ever had a baby, that you’re the only person who understands what internalized stigma feels like.
The conversation should start, continue, and end with the population that is living with HIV, but the onus is not on one group of folks — it’s going to take all of us to end this epidemic.
07 MEDIAPLANET READ MORE AT FUTUREOFPERSONALHEALTH.COM
INTERVIEW WITH Krista Martel Executive Director, The Well Project
INTERVIEW WITH Olivia G. Ford Editorial Director, The Well Project
INTERVIEW WITH Ciarra Covin Senior Manager of Community Programming, The Well Project
Having lived openly with HIV for 28 years, I get asked a lot of questions. I’m happy to answer them. It’s why I share my status: to help break the soul-crushing stigma and discrimination that can accompany HIV.
Significant scientific advances have been made since I was diagnosed 28 years ago. Then, I took 14 pills a day and was given a year to live. Now, one small pill daily keeps me on the planet, and I am trying to navigate how to grow old gracefully.
Data from the Joint United Nations Programme on HIV/ AIDS (UNAIDS) shows there are 39 million people living with HIV. The great news is that 29.8 million of them are accessing treatment. Treatment not only allows those of us with HIV to live healthy, long lives — it also serves as prevention. When a person’s
Lessons From a Life With HIV Phenomenal Progress and Enduring Emergency: 4 Decades of Fighting AIDS
HIV viral load is undetectable, HIV cannot be transmitted.
Unnecessary obstacles
Stigma and discrimination hinder our ability to reach the United Nations’ goal of ending the AIDS pandemic as a public health threat by 2030. The stigma that I face is compounded for people who are from marginalized communities. This is why for gay men and other men who have sex with men, people who inject drugs, transgender people, sex workers, and people in prisons, there is a disproportionate risk of HIV.
Ending AIDS requires that we overcome the inequalities and

disparities that make it dangerous, unaffordable, or impossible for millions of people at risk of or living with HIV to get the care they need and deserve.
I know the excruciating pain and hopelessness of being diagnosed with a terminal condition. Thankfully, I also know the joy and indescribable release that comes when it is no longer terminal — when science and compassion enable survival and give you a new lease on life. This experience should be universal for all people facing HIV.
I became an AIDS advocate, and work for UNAIDS, because I know that continued progress is possible if we can convince world leaders to extend kindness, support, and equitable access to care to all. The evidence is crystal clear: We can end AIDS and any pandemic only if we reach everyone, everywhere — including here in America. I’ll die trying to ensure that we do.
Written by Regan Hofmann, Senior Advisor, UNAIDS
The AIDS fight has experienced unimaginable progress in recent decades.
In 2000, just 685,000 people had access to antiretroviral therapy (ART). In 2022, 29.8 million people were living with HIV and accessing ART. Medication has gone from costing roughly $27 a day in 2000 to as little as 11 cents a day. AIDS-related deaths have been slashed by nearly 70% since their peak in 2004.
That’s the good news. The bad news is that AIDS — especially in low- and middle-income countries — remains a deadly crisis. The days of AIDS dominating newspaper headlines and leading nightly newscasts are long over. But the threat persists, and it’s as real as ever.
The path to ending AIDS
The medical solutions for ending the AIDS threat exist. Testing and
treatment have been available for decades. What’s missing is the will to get those life-saving tools from wealthy countries to people and communities in places where systemic injustice has enabled AIDS to thrive.
When AIDS dominated headlines in the early 2000s, the money followed. As public attention drifted elsewhere, government resources did, too. The world is spending about as much money fighting AIDS now as it was in 2013.
Along with wealthy countries, beneficiary countries must also step up and do more. In the early 2000s, many low- and middle-income countries increased domestic spending to combat AIDS. However, 2022 marked the third year in a row where
domestic HIV funding decreased. We must create a pathway that enables domestic countries to spend more on healthcare, and less on repaying old debts and mitigating the impacts of a climate crisis they did not cause. All investors want a good bet and global health investments are among the best around. Every dollar invested in tackling AIDS, tuberculosis, and malaria yields a return of $31 in health gains and economic returns. When governments, philanthropy, and the private sector unite to strengthen global health systems, increase capacity, and recruit and train more community health workers, they not only fight current epidemics, but also limit the risk of future debilitating pandemics.

08 MEDIAPLANET READ MORE AT FUTUREOFPERSONALHEALTH.COM
WRITTEN BY Jennifer Lotito President and COO, (RED)
Regan Hofmann with her horse, Boogie Man | Photo by Phyllis Dawson
Knowledgeable, Trained Healthcare Providers Are Vital for Quality HIV Care
HIV prevention and treatment has made incredible strides since the beginning of the AIDS epidemic in the 1980s. Now, people with HIV have a range of treatment options to use to keep the virus in check. This leads to people with HIV living longer, healthier lives once they achieve sustained viral suppression — health that can be comparable to someone without HIV.

Prevention also has come a long way. While the focus of HIV prevention used to be primarily on condom use and abstinence, now there are newer, more sophisticated weapons in the prevention arsenal. Today, people can take HIV pre-exposure prophylaxis (PrEP) medication, either as a daily pill or a long-acting injection. When taken as prescribed, PrEP can reduce the risk of HIV from sex by approximately 99%.1
Yet, even with all of these advances, we still have a long way to go in ending the HIV epidemic in the United States. According to statistics from the Centers for Disease Control and Prevention, about 1.2 million people in the United States have HIV, and there were approximately 32,100 new infections in 2021.2 This means that over a million Americans need knowledgeable, quality HIV care — and all Americans need informed, up-to-date sexual health care to ensure HIV prevention.
How the academy helps
The American Academy of HIV Medicine (AAHIVM) is the nation’s leading independent organization of healthcare professionals dedicated to providing excellence in HIV care and prevention. Our membership of practitioners and credentialed clinicians manage the health of the majority of people with and at risk for HIV in the United States. Our mission is to ensure healthcare professionals have the resources needed to provide prevention, treatment, and care for those with or at risk for HIV.
To that end, we provide education offerings for the whole healthcare team to ensure all providers are aware of the latest advances in treatment and prevention. For clinicians who focus on practicing HIV medicine, we offer professional certifications: HIV Specialist™, HIV Pharmacist™, and HIV Expert™. These credentials establish the standard for HIV
expertise among physicians, nurse practitioners, physician assistants/ associates, and pharmacists.
Academy resources for patients
To help patients connect with knowledgeable HIV providers, the Academy offers a provider directory where patients can search for practitioners in their area: providers.aahivm.org/ referral-link-search.
Patients can also learn more about the latest advances in HIV prevention, care, and treatment by listening to our podcast, the Academy Exchange, at podcast.aahivm.org. Episodes cover topics like PrEP, women and HIV, weight changes and HIV, the HIV care team, and more.
Academy resources for providers
We believe all providers should have free access to quality continuing education. Our education programs, online courses, and in-person workshops feature the latest data, research, and science to equip providers with the current clinical information they will need for their patients. We also accredit our educational offerings for physicians, physician assistants/associates, pharmacists, nurse practitioners, and nurses. Visit education.aahivm.org.
Perscribers can visit the Long-Acting Agents Resource Center, a single online source to find answers about long-acting agents, including prescribing, procurement, dispensing, coding, and third-party payer coverage. Learn more at hivlaa.org
Finally, all providers are encouraged to become Academy members. The Academy is the only HIV trade and nonprofit association that welcomes the entire healthcare team, creating an atmosphere of collaboration and insight.

Join the American Academy of HIV Medicine at aahivm.org/ membership

References
1. The Centers for Disease Control and Prevention. PreExposure Prophylaxis (PrEP). U.S. Department of Health and Human Services. Updated July 5, 2022. Accessed May 28, 2024. https://www.cdc.gov/ hiv/risk/prep/index.html
2. HIV.gov. U.S. Statistics. The Centers for Disease Control and Prevention. Updated December 7, 2023. Accessed May 28, 2024. https://www.hiv. gov/hiv-basics/overview/dataand-trends/statistics
09 MEDIAPLANET READ MORE AT FUTUREOFPERSONALHEALTH.COM
Sponsored
WRITTEN BY Bruce J. Packett II Executive Director, American Academy of HIV Medicine (AAHIVM)
Five Ways Employers Can Help End HIV
Ending the HIV epidemic in the United States is within reach, but only if all sectors, including employers, work together to make sure the most powerful HIV prevention and treatment tools reach the people in greatest need.
U.S. Business Action to End HIV — an initiative of the Health Action Alliance — unites companies like Mercer to leverage their resources, influence, and expertise to end the epidemic by 2030.
Scientific advancements, such as rapid HIV tests, PrEP medication to prevent getting HIV, and antiretroviral treatments that enable people to live healthy lives and prevent transmission to others, can drastically reduce new HIV cases. However, challenges remain, including access, misinformation, discrimination, and HIV stigma.
5 ways employers can help
1. Provide comprehensive medical coverage for HIV screening, prevention, and treatment.
2. Allow flexible time off for HIV-related medical appointments.
3. Foster an inclusive work environment by educating employees and reducing stigma.
4. Implement HIV non-discrimination workplace policies.
5. Collaborate with community organizations to improve access to HIV services.
The Health Action Alliance offers free tools and resources to help employers take action. And employers can amplify their impact by joining U.S. Business Action to End HIV. Take the first step at HealthAction.org/EndHIV.
Written by Caroline Jackson & Mario Harper, Directors, Health Action Alliance and U.S. Business Action to End HIV


Why HIV Is a Health
Equity Issue
Addressing health equity is on the agenda for many employers. Based on health and benefits consultant Mercer’s research, about 60% of large employers are doing something to address health equity, with most efforts focused on ensuring members can identify culturally competent providers and identifying gaps in care based on gender, race, or sexual orientation.
Because HIV has a disproportionate impact on Black, Latino, and LGBTQ+ communities, it is a perfect match for focused health equity efforts.
If you need a business case to convince you to take action, HIV treatment medication costs are more than double the preventive medication costs per year.
Your first question may be how to decide if this initiative is right for your company and your population. There are two places to start. First, take a look at your specialty pharmacy list. Chances are you will find several HIV prevention or treatment drugs on your top 10 specialty drug list. If you do not know how to tell, ask your pharmacy vendor partner for help.
Second, your geographic locations are also a great indicator. Check out the AIDSVu.org map created by Emory University with CDC data showing the rates of people living with HIV. See if you have people in the areas with the highest incidence rates. There are additional maps within the site that will help you better understand the geographic reach of the epidemic.
The good news is that resources exist to help employers do this work. U.S. Business Action to End HIV is a coalition that has already developed tools for employers.
Modern HIV prevention and treatment
HIV is no longer the death sentence it once was. Thanks to continuing medical advances, HIV can be controlled like other chronic health conditions, and people with HIV can live full, healthy lives. And prevention medications (called PrEP) offer people highly effective protection against HIV — if they know about it and can get it. Those receiving treatment and whose viral load is suppressed to undetectable levels cannot transmit HIV to their partners.
This year, take the opportunity to change lives for the better — put “eliminate HIV” on your health equity agenda.


10 MEDIAPLANET READ MORE AT FUTUREOFPERSONALHEALTH.COM
Sponsored
Mercer Learn more by reading Mercer’s US Health News Blog:
WRITTEN BY Tracy Watts Senior Partner, National Leader of U.S. Healthcare Policy,
Times have changed, HIV Criminalization Laws should too.
Since the 1980s, the HIV/AIDS landscape has undergone significant changes with dramatic improvements in the health and lifespan of people living with HIV. However, a lack of understanding of the virus remains — specifically misconceptions from the 1980s that led to widespread stigmatization and discrimination against people living with HIV.
How have the ‘80s-era myths continued to flourish in the present day? One blatant reason is that misinformation is cemented into state laws nationwide.
The majority of the United States has outdated HIV criminal codes, with many citing debunked science on HIV. According to the Centers for Disease Control and Prevention, 34 states have laws that criminalize HIV exposure, and “Many laws are now outdated and do not reflect our current understanding of HIV ... Further, these laws have been shown to increase stigma, exacerbate disparities, and may discourage HIV testing.”
For example, in Louisiana, a person living with HIV can receive a felony conviction and time in prison without proof of intention to expose HIV or evidence of transmitting the virus. HIV criminal policies are not just limited to state laws; they also have severe implications within the U.S. military. Ken Pinkela, a former Army lieutenant colonel, pledged his life to defend the rights and freedoms of people in the United States. He never thought that his own rights would be taken away after serving his country for 29 years, all due to claims based on outdated HIV criminal laws. Pinkela was dismissed from the Army and criminalized for an allegation of consensual sex because he was an HIV-positive servicemember.

“Any law or policy on a health status, like HIV, should uphold the rights and dignity of the people affected,” stated Pinkela, who is now an advocate for the “HIV Is Not A Crime” movement as a Council of Justice Leader for The Elizabeth Taylor AIDS Foundation (ETAF). “When a law potentially criminalizes behaviors that pose no actual risk of HIV exposure, it sends the message that our country prioritizes fear and hysteria over evidence-based understanding and compassion.”
Reversing
outdated laws and stigma
However, progress is being made to reverse these laws nationally and state-by-state. ETAF, alongside national partners including the Health Not Prisons Collective, the Center for HIV Law & Policy,
and the Williams Institute, has made tremendous strides in modernizing these antiquated laws. Ongoing efforts include grassroots mobilization of AIDS-service organizations and coalitions to change the laws from within each state, which has proven to be instrumental in changing the local stigma and education disparities of HIV.
We have seen recent success in states carrying the harshest criminal penalties, including Georgia, Tennessee, and Virginia. In July 2023, the state of Tennessee removed criminal HIV exposure from the list of offenses that require sex offender registration. Thanks to this change, ETAF’s Council of Justice Leader, Lashanda Salinas, was the first woman to celebrate her removal from the sex offender registry.
“I’m so proud of our community and that we’ve finally made some progress that directly changes my life as a person living with HIV for the better,” Salinas stated. “I hope that we can continue to modernize HIV policies in every state without setbacks due to ignorance. We are still educating lawmakers, media, and people in power about the science and treatment. It’s a huge education issue across the board.”
To


11 MEDIAPLANET READ MORE AT FUTUREOFPERSONALHEALTH.COM
Sponsored
movement,
learn more and support the HIV Is Not A Crime
please visit ETAF.org/HIVIsNotACrime
HIV Is Not A Crime is made possible by a grant from Gilead Sciences, Inc.
Photo by Sally Wolf, provided by The Elizabeth Taylor AIDS Foundation